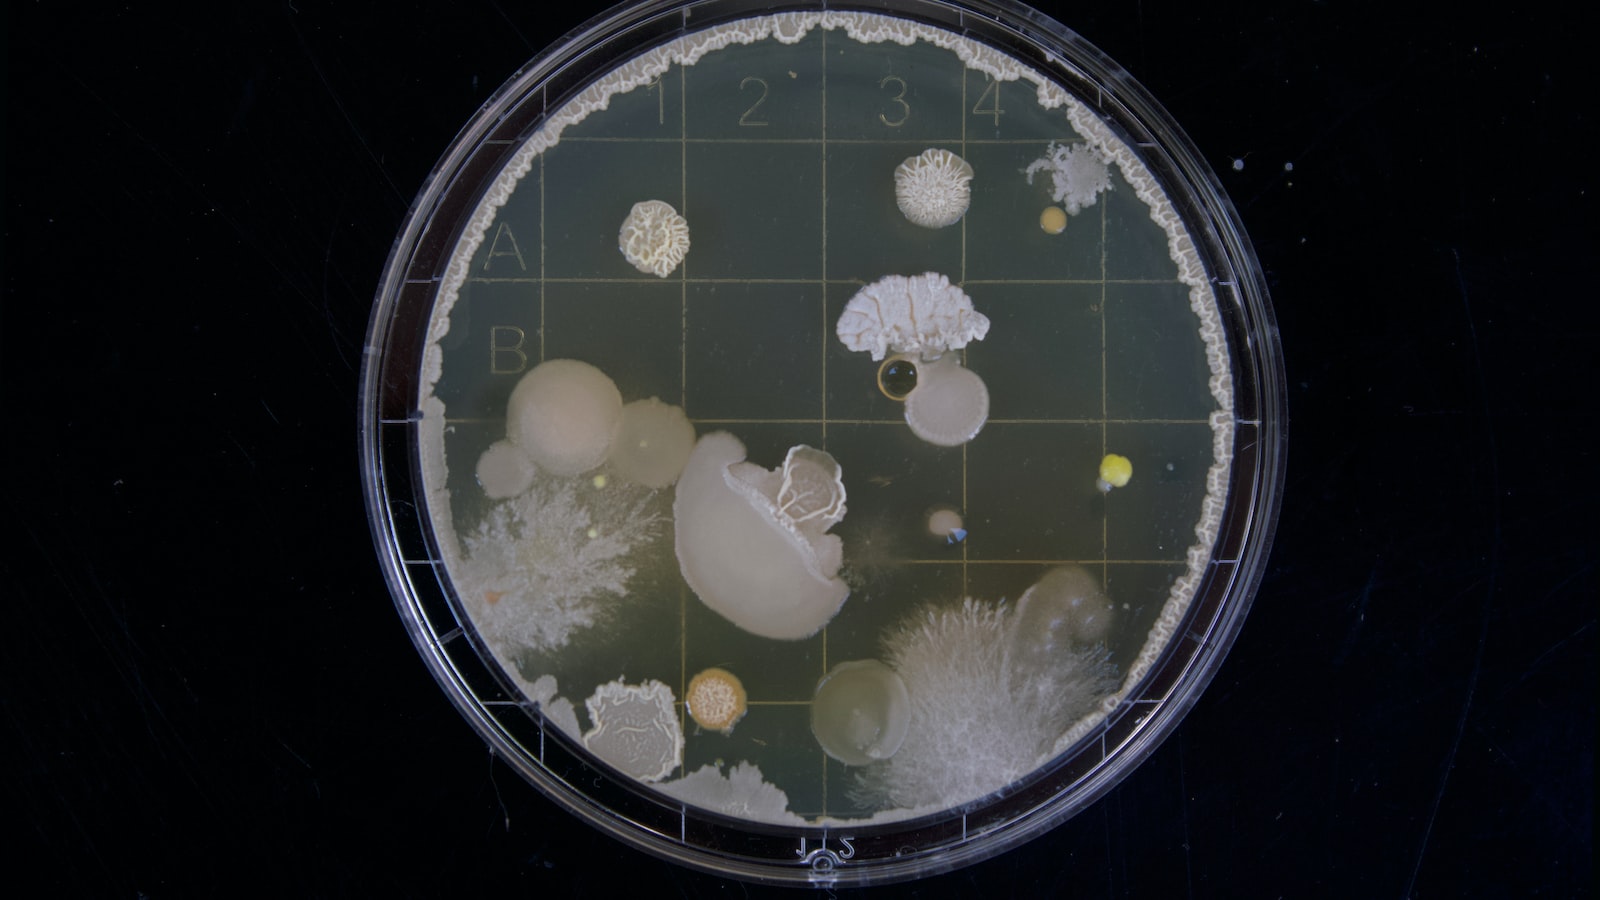
The Meaning of ‘Dissertation’ in English

What does it mean to write a dissertation? It’s something that countless college and university students around the world have gone through, spending weeks or even months researching, writing and ultimately submitting their thesis. For many of us, understanding what this process involves isn’t always easy – but here we will explore the meaning of ‘dissertation’ in English with an eye on uncovering everything that lies beneath its surface.
Understanding the Abstract and Scope
Before beginning to understand what dissertation means, it’s important to know its abstract and scope. A dissertation is a long essay on a particular subject, usually written by a student for an undergraduate or master’s degree. It is typically 60-100 pages in length but may be longer depending on the topic being researched. The research project can vary from theoretical exploration of hypothetical issues to empirical investigation of contemporary topics; either way, the goal is to add something new and valuable to existing knowledge.
To explain further, here are some aspects that make up a typical thesis:
When considering the differences between a dissertation and other types of writing, one must first understand what a dissertation means. A dissertation is an original contribution to knowledge in any given field at postgraduate level. It involves independent research under guidance from advisors or tutors.
A thesis differs distinctly from other forms of academic writing in several ways – it requires much deeper research than most papers; it has specific structural requirements; and also tends to be written with more formality. The main focus on this type of project is mustering evidence and facts that help support an argument while displaying the researcher’s own analytical insights into the topic being explored.
A dissertation is traditionally defined as a research document presented by a student of higher education to demonstrate their mastery and comprehension of a particular topic. A successful dissertation will require the author to clearly articulate why they have chosen this specific project, what objectives it seeks to achieve, and how these goals will benefit both themselves personally, academically or professionally. In short: if you are writing your thesis and intend for it be well-received then it needs define its mandate; otherwise your effort can appear unfocused or lack direction.
With that said there are various different ways one might approach producing an effective dissertation based upon desired outcomes. It could take on the form of historical analysis or remain firmly entrenched within contemporary debates – but no matter which path you choose to take accuracy and clarity must always remain at its core in order for readers (and potential employers) understand precisely what, why, where ,when , and howthe project applies itself towards addressing any given problem.
It is therefore essential that authors consider exactly what their goal is when creating such work so that they can properly arrange resources appropriately while simultaneously orienting readers arounds key discussion points throughout each chapter. Intensive deliberation should fall into three distinct phases before going further down any academic avenue: identifying viable topics related to found interest areas; deciding which framework best serves those interests; developing those concepts through rigorous scrutiny using empirical data collected from reliable sources.
The dissertation is a long form of academic writing that enables a student to provide an in-depth exploration into a specific subject. It involves presenting the research undertaken by the student, supported with evidence and arguments leading to an original hypothesis or conclusion. What dissertation means is it allows students to demonstrate their ability to think critically, identify key areas of inquiry, conduct extensive research on those topics while articulating findings through both written and oral mediums.
Structuring your work properly for presentation is important as it conveys impactful and organized information which makes it easier for readers grasp concepts quickly. As such, when creating projects like dissertations – clear headings and subheadings should be used throughout sections; tables/graphs should be appropriately incorporated along with relevant visuals – all these elements are vital aspects of successful structuring. Unordered lists can also help keep track of ideas while providing visual aids so readers can comprehend what they are reading more easily.
The goal here is to clearly present every aspect necessary for understanding what dissertation means: developing hypotheses / thesis statements; exploring supporting arguments; summarizing key points in conclusion(s); etc.
In any research project, especially when writing a dissertation, it is important to understand what sources are available and which ones should be used for the best results. It can often be difficult to determine the difference between primary or secondary sources of information, and how these two types of data will affect your research findings.
To begin with, a primary source is one that provides firsthand knowledge about a subject matter from those who have direct experience with it. For example, interviews conducted by researchers as part of their dissertation work would constitute primary resources since they originate from people involved in the topic being studied. Additionally, first-hand accounts such as diaries or autobiographies could provide valuable insight into an event or occurrence and thus be considered primary sources too.
Conversely, secondary sources serve as interpretations or evaluations about subjects based on other authors’ works rather than personal experiences. This type of resource may include analyses written by experts for particular topics; books reviewing previous studies done on certain areas; newspaper articles reporting current events related to subjects like economics; etc.
When researching topics for your dissertation then understanding what types of resources are most appropriate is essential in order to produce valid conclusions backed up by reliable evidence supporting them–what this means is that you must know when to pick one type over another depending on what kind of data you need in order make meaning out of your findings through interpreting collected information properly.
Developing a dissertation can be daunting and challenging, as you must create a piece of original research that is then evaluated through the use of accepted academic standards. A few common challenges are faced by students when it comes to developing an effective dissertation, each one requiring its own approach in order to ensure maximum success.
In addition to these two primary obstacles there are several other considerations which could challenge what does dissertaion means most students. Crafting clear research questions requires careful consideration and balancing between objectives – something which usually takes more time than initially anticipated. Additionally, combining multiple sources into coherent arguments whilst maintaining accurate citations carries risk for plagiarism if not correctly managed throughout what does disseration meansthe entire writing process. Finally ensuring requirements set out by your department or institution concerning structure/content relevancy will need strict adherence during all stages of production; otherwise revisions may be required later down the line once everything has been completed This concept was incredibly useful for my understanding in relation to how I should format my essay
what does disseration mean Moreover over-reliance upon external sources within the work is yet another challenge that needs careful management at all times; this especially applies towards previously published material from online repositories and journals
When preparing your dissertation for successful submission and publication, there are several steps you need to take. Firstly, it’s important to ensure that the content is of a very high quality from an academic standpoint. This means using reliable sources when conducting research in order to support your work with solid evidence. As part of this process, check that what dissertation means by ensuring all references are included throughout the text correctly. It also helps rely on software like grammarly or turnitin as tools used by many reviewers before final submission and assessment of scholarly works.
Once you are confident about the quality and accuracy of information being provided in your paper, begin focusing on formatting guidelines specified by both publishers and institutions alike – especially if submitting through databases such as ProQuest or EBSCOhost which have their own prerequisites for papers accepted into major collections online (eg APA). Pay attention not only to citation styles but margins/spacing; font size/style (e.g., Times New Roman 12 pt.), use tables/figures appropriately; include numberings clearly displayed; emphasise key points using bolding where appropriate – enabling readability while still meeting requirements necessary. Furthermore, be sure to number sections so readers can easily locate particular areas within writing itself making what dissertation means more accessible than ever before! Understanding the meaning of ‘dissertation’ in English can open up a world of opportunities. Whether it’s to extend your knowledge, explore research methods or complete an academic qualification – this word is essential for anyone engaging with higher education. As you embark on writing your dissertation, remember that the potential rewards far outweigh any challenge encountered along the way!